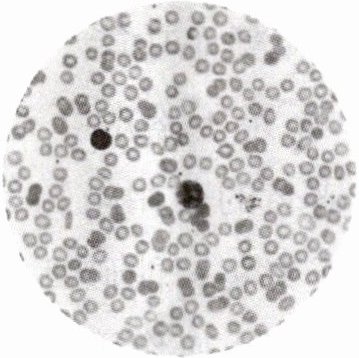

1. 观察人血的永久涂片
将人血的永久涂片放在显微镜下观察,对照下图,识别不同的血细胞。
通过观察,可以发现血细胞中数量最多的是
将人血的永久涂片放在显微镜下观察,对照下图,识别不同的血细胞。
通过观察,可以发现血细胞中数量最多的是
红细胞
;白细胞
数量比较少,体积通常比较大;血小板
体积最小,一般不容易看到。
答案:
红细胞 白细胞 血小板
2. 观察小鱼尾鳍内血管及血液的流动
(1)选材:尾鳍色素
(2)步骤:
①包裹小鱼——用
②安放小鱼——将小鱼平放在培养皿中,使尾鳍平贴在培养皿上。鱼在培养皿中会跳动,可以在鱼安静后,将
③观察——将培养皿放在载物台上,用
(1)选材:尾鳍色素
少
的活的小鱼,便于观察。(2)步骤:
①包裹小鱼——用
湿
纱布将小鱼头部的鳃盖和躯干包裹起来,露出口和尾部。②安放小鱼——将小鱼平放在培养皿中,使尾鳍平贴在培养皿上。鱼在培养皿中会跳动,可以在鱼安静后,将
载玻片
盖在尾鳍上。③观察——将培养皿放在载物台上,用
显微镜
观察尾鳍血管内血液的流动情况。共观察到三种血管,其中管径最小、红细胞单行通过且血流速度最慢的血管是毛细血管
;动脉
分支形成毛细血管,血流速度快,毛细血管最终汇入静脉
,血流速度较慢。
答案:
(1) 少
(2) ①湿 ②载玻片 ③显微镜 毛细血管 动脉 静脉
(1) 少
(2) ①湿 ②载玻片 ③显微镜 毛细血管 动脉 静脉
3. 在医院做检查时,有时医生会从被检查者的手指上取一滴血,然后将血滴在载玻片上制成玻片标本,放在显微镜下观察。医生制作的这种血液玻片标本属于(
A. 临时切片
B. 临时装片
C. 临时涂片
D. 永久涂片
C
)A. 临时切片
B. 临时装片
C. 临时涂片
D. 永久涂片
答案:
C
4. 为积极响应国家支援西藏建设的号召,某校教师主动申请前往西藏任教。西藏高原地区含氧量比较低,长期生活在平原地区的教师们进入西藏高原地区初期,血液中细胞数目会显著增加的是(
A. 红细胞
B. 白细胞
C. 血小板
D. 血浆
A
)A. 红细胞
B. 白细胞
C. 血小板
D. 血浆
答案:
A
5. 下图是显微镜下的人血细胞视野图。下列叙述错误的是(

A. 血液由图中的①②③④组成
B. 人体出现炎症时,②的数量会增多
C. ③的形状不规则,有止血和凝血功能
D. ②和③都不能用来做 DNA 亲子鉴定
D
)A. 血液由图中的①②③④组成
B. 人体出现炎症时,②的数量会增多
C. ③的形状不规则,有止血和凝血功能
D. ②和③都不能用来做 DNA 亲子鉴定
答案:
D
查看更多完整答案,请扫码查看